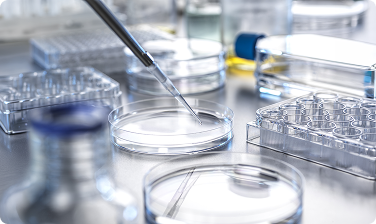

CONTENTS
-
 Interview
스토리 R
세상에 없던 반도체의 등장,
Interview
스토리 R
세상에 없던 반도체의 등장,
계산과 기억의 경계를 허물다연세대학교 심우영 교수
-
 Interview
뉴-페이스
손상된 인체조직 되살리는
Interview
뉴-페이스
손상된 인체조직 되살리는
의공학자성균관대학교 신미경 교수
-
 Issue
연구모음.ZIP
미시세계에서 이뤄지는 마법
Issue
연구모음.ZIP
미시세계에서 이뤄지는 마법
#DNA_RNA -
 Interview
사유의 서재
시대를 휘몰아친 문학을 찾는 당신께
Interview
사유의 서재
시대를 휘몰아친 문학을 찾는 당신께
「광장의 문학」김진영 前 연세대학교 교수
-
 Issue
트렌드리포트
세계는 지금
Issue
트렌드리포트
세계는 지금
: 컴퓨터와 뇌를 연결하시겠습니까? -
Issue
News N
대학기초연구소 지원사업(G-LAMP)
Issue
News N
대학기초연구소 지원사업(G-LAMP)
신규과제 준비 전 알아둬야 할 A to Z -
 Media
밸런스 실험실
알쏭달쏭, 너와 나의 밸런스!
Media
밸런스 실험실
알쏭달쏭, 너와 나의 밸런스!
각양각색? AI와 대화하는 우리의 모습

